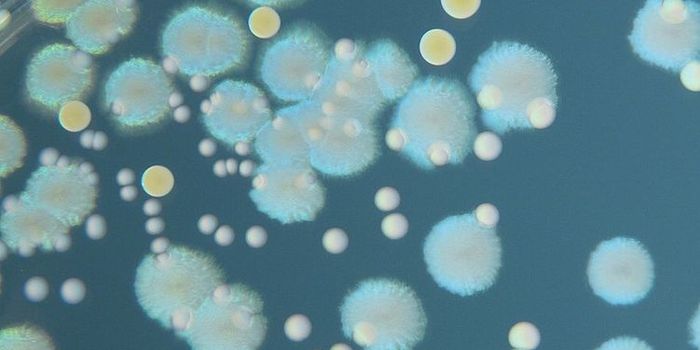
New Generation of Antibiotics Kills Bacteria with Impeccable Precision

Molecular Microbiology
Molecular Microbiology: The Division of Molecular Microbiology encompasses a spectrum of research that flows from fundamental science using model organisms to translational research on medically- and economically-significant species. The overarching purpose of the division is to further the science of molecular microbiology through innovative and internationally-recognized research on a broad platform of topics.
-
NOV 28, 2017MicrobiologyExtreme microbes are organisms that can survive and even thrive in extreme environments. Extreme thermophiles are bacter ...Written By: Sarah HertrichNOV 25, 2017Cell & Molecular BiologyAntibiotic resistance is a growing health problem, one that already kills an estimated 23,000 people every year in the U ...Written By: Carmen LeitchNOV 21, 2017ImmunologyA new discovery of how specialized immune cells carry out their last resort effort to kill pathogens could help scientis ...Written By: Kara MarkerNOV 21, 2017MicrobiologyHuman norovirus was originally called Norwalk virus after the town of Norwalk, OH where the first confirmed outbreak occ ...Written By: Sarah HertrichNOV 18, 2017ImmunologyWithout the inflammasome, the immune response to invading pathogens would be severely flawed. This protein conglomerate ...Written By: Kara MarkerNOV 16, 2017Genetics & GenomicsGenome editing, now inspired by yeast, aims to turn a 'hacksaw to a scalpel.'Written By: Carmen LeitchNOV 16, 2017MicrobiologyCandida auris is a type of yeast identified as an opportunistic pathogen that can cause severe illness in hospitalized p ...Written By: Sarah HertrichNOV 14, 2017ImmunologyThe Zika virus is mostly portrayed in the media as an ultra dangerous infection that causes all sorts of problems in tho ...Written By: Kara MarkerNOV 13, 2017TechnologyThrough high-speed atomic-force microscopy, the scientists take us on an incredible journey into the realm of CRISPR at ...Written By: Julia TraversNOV 11, 2017MicrobiologyMethicillin-resistant Staphylococcus aureus, also known as MRSA, is a type of antibiotic resistant bacteria that causes ...Written By: Sarah HertrichNOV 10, 2017MicrobiologyChronic wasting disease (CWD) is a contagious neurological disorder that affects deer, elk, reindeer, and moose that lea ...Written By: Sarah HertrichNOV 10, 2017ImmunologyThe only way to overcome multidrug-resistant bacteria is to design a drug that bacteria have never encountered. In a new ...Written By: Kara MarkerNOV 08, 2017MicrobiologyOver the last several decades the growth of the aquaculture industry has accelerated. Aquaculture can be defined as the ...Written By: Sarah HertrichNOV 06, 2017ImmunologyAround the world pregnant women and their babies are at risk of a bacterial infection that is a major cause of maternal ...Written By: Kara MarkerNOV 03, 2017CardiologyIt’s not just fat and cholesterol that we get from our diet that contributes to heart disease. Bacteria that live ...Written By: Kara MarkerNOV 02, 2017Clinical & Molecular DXPSA: Rabies is not a minor illness that will go away on its own. One person in Florida recently contracted rabies from a ...OCT 27, 2017Clinical & Molecular DXMadagascar is currently battling a plague outbreak that has so far infected nearly 1,200 people and killed 124 people. I ...OCT 26, 2017Cell & Molecular BiologyWe carry many microbes in and on our bodies. Researchers have now found a mechanistic link between these microbes and di ...Written By: Carmen LeitchOCT 22, 2017Cell & Molecular BiologyPowerful microscopy techniques have given researchers unprecedented insight into how a common class of receptors works.Written By: Carmen LeitchOCT 20, 2017MicrobiologyThe local food movement, with origins dating back to the 1930s, aims at influencing consumers to purchase food that has ...Written By: Sarah HertrichOCT 19, 2017Health & MedicineFor the first time, researchers dare to suggest they may have found a functional cure for HIV, the viral infection that ...Written By: Kara MarkerOCT 18, 2017Clinical & Molecular DXIf any new moms out there have reservations about whether or not to consume the placenta after birth, a newly published ...OCT 17, 2017ImmunologyThe influenza vaccine may not be as effective as it needs to be for young leukemia patients, who are at an especially hi ...Written By: Kara MarkerOCT 16, 2017ImmunologyNorovirus is infamous for its invasion of cruise ships, daycares, and other places where a viral infection is particular ...Written By: Kara Marker
NOV 28, 2017
Microbiology
Extreme microbes are organisms that can survive and even thrive in extreme environments. Extreme thermophiles are bacter
...
Written By:
Sarah Hertrich
NOV 25, 2017
Cell & Molecular Biology
Antibiotic resistance is a growing health problem, one that already kills an estimated 23,000 people every year in the U
...
Written By:
Carmen Leitch
NOV 21, 2017
Immunology
A new discovery of how specialized immune cells carry out their last resort effort to kill pathogens could help scientis
...
Written By:
Kara Marker
NOV 21, 2017
Microbiology
Human norovirus was originally called Norwalk virus after the town of Norwalk, OH where the first confirmed outbreak occ
...
Written By:
Sarah Hertrich
NOV 18, 2017
Immunology
Without the inflammasome, the immune response to invading pathogens would be severely flawed. This protein conglomerate
...
Written By:
Kara Marker
NOV 16, 2017
Genetics & Genomics
Genome editing, now inspired by yeast, aims to turn a 'hacksaw to a scalpel.'
Written By:
Carmen Leitch
NOV 16, 2017
Microbiology
Candida auris is a type of yeast identified as an opportunistic pathogen that can cause severe illness in hospitalized p
...
Written By:
Sarah Hertrich
NOV 14, 2017
Immunology
The Zika virus is mostly portrayed in the media as an ultra dangerous infection that causes all sorts of problems in tho
...
Written By:
Kara Marker
NOV 13, 2017
Technology
Through high-speed atomic-force microscopy, the scientists take us on an incredible journey into the realm of CRISPR at
...
Written By:
Julia Travers
NOV 11, 2017
Microbiology
Methicillin-resistant Staphylococcus aureus, also known as MRSA, is a type of antibiotic resistant bacteria that causes
...
Written By:
Sarah Hertrich
NOV 10, 2017
Microbiology
Chronic wasting disease (CWD) is a contagious neurological disorder that affects deer, elk, reindeer, and moose that lea
...
Written By:
Sarah Hertrich
NOV 10, 2017
Immunology
The only way to overcome multidrug-resistant bacteria is to design a drug that bacteria have never encountered. In a new
...
Written By:
Kara Marker
NOV 08, 2017
Microbiology
Over the last several decades the growth of the aquaculture industry has accelerated. Aquaculture can be defined as the
...
Written By:
Sarah Hertrich
NOV 06, 2017
Immunology
Around the world pregnant women and their babies are at risk of a bacterial infection that is a major cause of maternal
...
Written By:
Kara Marker
NOV 03, 2017
Cardiology
It’s not just fat and cholesterol that we get from our diet that contributes to heart disease. Bacteria that live
...
Written By:
Kara Marker
NOV 02, 2017
Clinical & Molecular DX
PSA: Rabies is not a minor illness that will go away on its own. One person in Florida recently contracted rabies from a
...
OCT 27, 2017
Clinical & Molecular DX
Madagascar is currently battling a plague outbreak that has so far infected nearly 1,200 people and killed 124 people. I
...
OCT 26, 2017
Cell & Molecular Biology
We carry many microbes in and on our bodies. Researchers have now found a mechanistic link between these microbes and di
...
Written By:
Carmen Leitch
OCT 22, 2017
Cell & Molecular Biology
Powerful microscopy techniques have given researchers unprecedented insight into how a common class of receptors works.
Written By:
Carmen Leitch
OCT 20, 2017
Microbiology
The local food movement, with origins dating back to the 1930s, aims at influencing consumers to purchase food that has
...
Written By:
Sarah Hertrich
OCT 19, 2017
Health & Medicine
For the first time, researchers dare to suggest they may have found a functional cure for HIV, the viral infection that
...
Written By:
Kara Marker
OCT 18, 2017
Clinical & Molecular DX
If any new moms out there have reservations about whether or not to consume the placenta after birth, a newly published
...
OCT 17, 2017
Immunology
The influenza vaccine may not be as effective as it needs to be for young leukemia patients, who are at an especially hi
...
Written By:
Kara Marker
OCT 16, 2017
Immunology
Norovirus is infamous for its invasion of cruise ships, daycares, and other places where a viral infection is particular
...
Written By:
Kara Marker